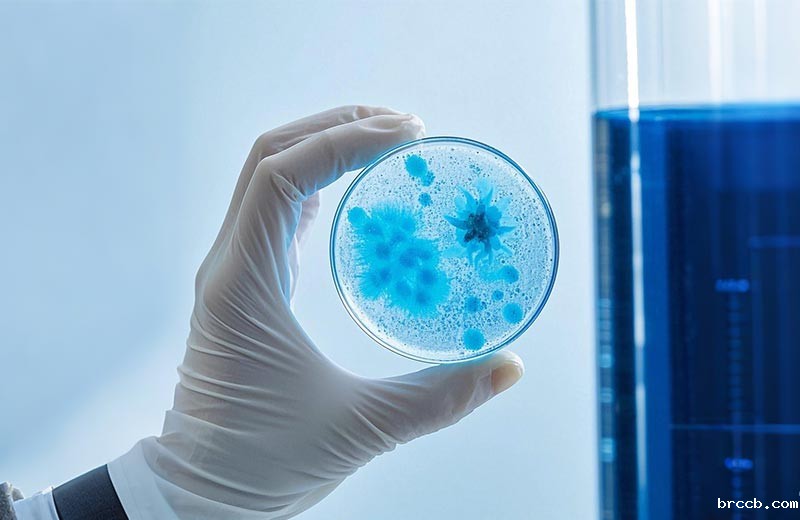

多功能水质快速测定仪在工农业、环保监测及家庭用水以及水处理行业等领域的需求显著增长。面对市场上琳琅满目的产品,如何选择蓟州水质快速测定仪一款性能操作便捷、可靠的仪器成为消费者关注的焦点,目前搭载进口光源及传感器和先进的光学结构设计比色采用的360°旋转比色方式,能为测定数据提升稳定性,有效解决了管壁划伤带来的测试误差,并自动测试数据至云平台,在云端存储,从而从移动或电脑端实时远程共享云平台中的数据记录,从而集成水质分析、光度测量、引导式检测、批量检测、自曲线、批量导出、数据批量打印等多种应用程序。
传感器与试剂系统的可靠性
-传感器类型:光学传感器(如分光光度法)适合实验室环境,而工业现场更推荐抗干扰能力强的电化学传感器。某德国品牌采用三电极系统,使用寿命达5万次以上。
-试剂兼容性:封闭式试剂包虽操作简便但成本较高(单次检测约8-15元),开放式试剂系统可降低60%耗材费用但需严格遵循配制流程。建议选择支持两种模式的机型。
-防污染设计:观察样品池是否具备自动冲洗功能,流动注射分析(FIA)技术可减少交叉污染风险。
智能化与数据管理能力
2025年智能水质检测设备市场规模预计突破80亿元,现代仪器应具备:
-无线传输:支持蓝牙5.0或Wi-Fi6,直接对接环保部门监测平台
-数据追溯:存储容量建议≥10万组,带时间戳和GPS定位功能
-异常预警:如某国产高端型号可基于历史数据预测水质变化趋势
在选购多功能水质快速测定仪时应该注意什么?
-确定需求:明确您需要测定仪的目的和使用场景,这将帮助您选择符合需求的型号,避免过度消费。
-比较品牌与型号:对比不同品牌和型号的测定仪,考虑它们的性能、用户评价和价格,以找到性价比高的选项。
-核实准确性和稳定性:查看产品的技术规格,确认其准确性和稳定性是否符合国家或国际标准。
-注意售后服务:了解厂家提供的售后服务内容,包括保修期限、技术支持和维修服务等。良好的售后服务可以在您遇到问题时提供帮助。
-考虑额外成本:考虑到后期可能产生的额外成本,如耗材更换、维护费用等,评估总体拥有成本。
总而言之选择一款合适的星空体育平台下载,需要从需求出发,综合考虑技术性能、智能化程度、品牌信誉及成本效益等多方面因素。只有这样,我们才能确保所选仪器既能精准反映水质状况,又能为我们的健康和生活质量提供有力保障。
本文标题:多功能水质快速测定仪选购注意事项
本文连接://www.brccb.com/news/12124.html
 猜您喜欢以下内容:
猜您喜欢以下内容:
- 便携式污泥浓度计的应用领域与技术参数2022-11-16 13:59:57
- 携带式水质分析仪的技术特点与使用范围2022-11-19 17:15:03
- 在线浊度仪工作原理2023-05-22 17:07:26


